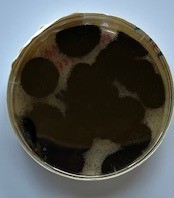

Fachvortrag
Fungizide Wirksamkeit von alkoholischen Desinfektionsmitteln
Vortrag wird aufgezeichnet!
Vortrag wird aufgezeichnet!
Alkohole wie Propan-2-ol oder Ethanol werden in der Kontaminationskontrolle bei pharmazeutischen Prozessen häufig eingesetzt.
Interessanterweise können Produkte für identische Formulierungen aus 70 % (v/v) Propan-2-ol unterschiedliche Wirksamkeiten gegen Pilze angeben, d. h. levurozide oder fungizide Wirksamkeit.
Der Einfluss der in EN 1650 im Jahr 2013 festgelegten Kultivierung von A. brasiliensis wurde im Vergleich zu früheren Versionen der EN 1650 untersucht. Die Daten zeigten signifikante Unterschiede in der Wirksamkeit von 70 % (v/v) Propan-2-ol gegen A. brasiliensis sowie keine signifikanten Unterschiede für 80 % (v/v) Ethanol.
Referent*innen:

Prof. Dr. Katrin Steinhauer